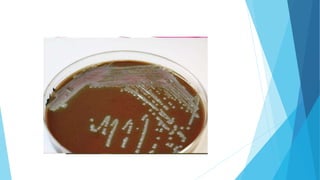

This document provides an overview of microbiology. It begins with defining microbiology as the study of microorganisms too small to be seen with the naked eye, including bacteria, viruses, fungi and protozoa. It then discusses the history and development of microbiology, including key figures like Leeuwenhoek, Pasteur, Koch, and others who helped prove germ theory and refute spontaneous generation. The document also classifies microbiology, explains the scope of the field in areas like medicine, agriculture and industry, and defines the differences between prokaryotic and eukaryotic cells.